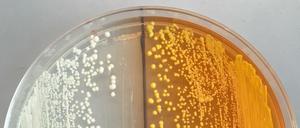
Neue, gentechnisch veränderte Hefezellen produzieren Vorläufer für Opiate (gelb gefärbt). Das kann die Herstellung von Arzneimitteln wie Morphin oder Antibiotika erleichtertn, eröffnet jedoch auch neue Möglichkeiten für die Herstellung illegaler Drogen.

Vor der Küste Kaliforniens ist ein Delfin in ein Boot mit einer Familie gesprungen - eine Frau wurde dabei verletzt. Das Boot war voller Blut, die Frau hatte Angst um das Tier und ihre Familie.

Vor der Küste Kaliforniens ist ein Delfin in ein Boot mit einer Familie gesprungen - eine Frau wurde dabei verletzt. Das Boot war voller Blut, die Frau hatte Angst um das Tier und ihre Familie.

Giuseppe Caire kam von L. A. nach Berlin. Er will die Datenübertragung schneller und effizienter gestalten.

Angela Ittel über Chancen und Anforderungen an künftige Berufsschullehrer. Bundesweit sind sie gefragt

Die Komponisten der Filmmusik stehen immer ein bisschen im Schatten der Regisseure, der Schauspieler sowieso. Dabei haben solche wie James Horner Hollywood mehr geprägt als mancher Filmemacher. Er gehörte zu den Stars der Zunft - die sich jetzt vor ihm verneigt.

Ban-Xeo-Pfannkuchen, Chung-King-Nudeln, Naan-Sandwiches, Pulled-Pork-Burger – die Streetfoodszene wird vielfältiger. Und die genialen Dilettanten von einst werden immer professioneller. Ein Überblick.

Neue Story, neue Besetzung: Die zweite Staffel von „True Detective“. Sind Colin Farrell und Vince Vaughn wirklich so gut wie Matthew McConaughey und Woody Harrelson?

Neue Story, neue Besetzung: Die zweite Staffel von „True Detective“. Sind Colin Farrell und Vince Vaughn wirklich so gut wie Matthew McConaughey und Woody Harrelson?

In Kalifornien sind die Strände derzeit überzogen mit toten Krabben. Schuld daran soll das Klimaphänomen El Niño sein.

4800 Kilometer mit dem Fahrrad in zwölf Tagen: Das ist das Extrem-Radrennen „Race across America“. Der 63 Jahre alte Achim Heukemes aus Bayern will nicht nur die Zielline überqueren - er will auch einen Rekord.

Nicht einmal Basketball-Superstar LeBron James konnte sie stoppen: Die Golden State Warriors gewinnen im sechsten Finalspiel gegen die Cleveland Cavaliers und holen den ersten Titel seit 1975 nach Kalifornien.

Seine Projekte ließen die Welt staunen: verhüllter Reichstag, Ölfasser in Paris und pinke Textilinseln vor Florida. Heute feiert der Künstler Christo Vladimirov Javacheff seinen 80. Geburtstag.

Gründergeist gibt es in Berlin genauso wie im Silicon Valley. Was Berlin aber von Kalifornien unterscheidet: Ein großer Mangel an IT-Forschung neben der bloßen Anwendung. Berlin hat die Chance, sich zur europäischen Digitalhauptstadt zu entwickeln - wenn jetzt das Richtige getan wird.

Die Westküstenstadt hat die höchste Lebensqualität der USA, die Menschen hier sind fit und selbstironisch. Ein Paradies? Nicht ganz.

Bei der Auktion der Villa Grisebach kamen Werke von Van Gogh, Pechstein und Riefenstahl unter den Hammer. Nicht wenige durchbrachen die geschätzten Werte um ein Vielfaches. Einzig die zeitgenössischen Künstler enttäuschten am Ende.

Verspielter Pop aus Kalifornien: Piu, piu, macht das Pocket-Piano, dong, dong, macht die Pauke, klack, klack der Drum-Computer. Und dazu singt die Leadsängerin Merrill Garbus.

Start der Finalserie in der nordamerikanischen Basketballliga: Die Golden State Warriors revolutionieren die NBA – und wollen gegen die Cleveland Cavaliers mit Dreiern den Titel holen.

Die USA sind Europa in vielem voraus, sagt Günther Oettinger, vor allem bei der Digitalisierung. Aber der EU-Kommissar hat eine Idee für die Aufholjagd. Ein Ortstermin.

Knapp siebeneinhalb Stunden hat sie gebraucht - und doch einen Rekord erzielt: Harriette Thompson ist die älteste Frau, die jemals einen Marathon absolvierte.

In den vergangenen zehn Jahren sind die Studiengebühren in Kalifornien um das Dreifache gestiegen. Jetzt werden die Gebühren an der University of California eingefroren. Dafür zahlt der Staat mehr Geld.

In Kalifornien sind erneut Strände wegen Ölverschmutzung gesperrt worden. Es ist der zweite Zwischenfall im US-Bundesstaat Kalifornien in rund zehn Tagen.

Sie hat ein Kino, zwei Seen und sogar einen eigenen Bahnhof: die ehemalige Neverland-Ranch von Michael Jackson. Jetzt steht das Luxus-Anwesen zum Verkauf.

So deutlich wie noch nie deutet ein Apple-Manager öffentlich an, dass der iPhone-Konzern ein Auto planen könnte. Schließlich sei das „das ultimative Mobil-Gerät“.
Meine Frau kann ja von Glück sagen, dass wir nicht in Beverly Hills wohnen. Da würde sie sich ganz schön umgucken.

Gronkh, LeFloid, Melissa Lee haben Millionen Fans. Viele Youtube-Stars spielen und kommentieren Computerspiele. Andere geben Beautytipps oder machen Comedy. Eine Zauberformel für Ruhm gibt es wie so häufig nicht.

Gronkh, LeFloid, Melissa Lee haben Millionen Fans. Viele Youtube-Stars spielen und kommentieren Computerspiele. Andere geben Beautytipps oder machen Comedy. Eine Zauberformel für Ruhm gibt es wie so häufig nicht.

Vor der Küste Kaliforniens schwimmt nach einem Pipeline-Bruch ein 23 Quadratkilometer großer Ölteppich im Meer. Malerische Strände sind betroffen und werden geschlossen.

Über 14 Kilometer erstreckt sich mittlerweile ein Ölteppich an der Küste Kaliforniens vor Santa Barbara. 400 000 Liter Öl sollen nach einem Schaden an der Pipeline ausgelaufen, fast ein Viertel davon sogar ins Meer gelangt sein.

Der unbemannte Minishuttle der US Air Force hebt in Cape Canaveral ab. Er soll einen "Hall-Antrieb" testen. Außerdem bringt die Rakete den Prototypen eines Lichtsegels in den Orbit.

Ölpest im US-Bundesstaat Kalifornien: Durch ein Leck in einer Pipeline sind etwa 80.000 Liter Eröl ausgelaufen. Der Ölteppich vor der Küste von Santa Barbara ist mehr als sechs Kilometer lang.

Spiegelneuronen gelten als Basis für Mitgefühl, Kultur und Sprache. Doch immer mehr Forscher haben Zweifel, ob der Hype überhaupt gerechtfertigt ist. Denn die Belege sind widersprüchlich.
Morphin, Heroin - bislang werden Opiate aus Schlafmohn gewonnen. Mit einer neuartigen Hefe könnten die Drogen künftig so wie beim Bierbrauen produziert werden.
Im Juni kommt Arnold Schwarzenegger nach Berlin um die Premiere von "Terminator Genisis" zu feiern. Auch Regisseur Alan Taylor, sowie Emilia Clarke kommt mit. Außerdem wird in den kommenden Wochen Melissa McCarthy Berlin besuchen.

Der US-Extremsportler Dean Potter ist bei einem "Base-Jump", einem Fallschirmsprung aus 900 Metern, ums Leben gekommen. Auch ein weiterer Mann starb bei dem Unfall im Yosemite-Tal in Kalifornien.

Sie hat sich für Folteropfer und politische Gefangene engagiert und den Dissidenten Vaclav Havel ins Konzert hineingeschmuggelt. Am 21. Mai wird Joan Baez in Berlin von Amnesty International geehrt. Ein Interview mit der Sängerin, Menschenrechtsaktivistin und Queen of Folk.
Die Anaheim Ducks sind auch ohne den deutschen Eishockey-Verteidiger Korbinian Holzer ins Halbfinale der NHL eingezogen.
Der Internetkonzern Google will mit Know-how und viel Geld dem europäischen Journalismus helfen. Auch der Tagesspiegel ist Teil der „Digital News Initiative“. Doch was hat Google im Sinn? Und was kann Facebook davon lernen?

Der Internetkonzern Google will mit Know-how und viel Geld dem europäischen Journalismus helfen. Auch der Tagesspiegel ist Teil der „Digital News Initiative“. Doch was hat Google im Sinn? Und was kann Facebook davon lernen?
Die 95-jährige Marthe Cohn spionierte im Zweiten Weltkrieg gegen Nazi-Deutschland. Am Gymnasium Hermannswerder berichtete sie jetzt Schülern davon

Das Erdbeben in Nepal könnte ein Weckruf sein: Nach der Nothilfe für die Opfer der Katastrophe muss die internationale Gemeinschaft den Bewohnern des armen Landes auf Dauer helfen, ein menschenwürdiges Leben zu führen. Ein Kommentar.

Vampirin mit Moral: Ana Lily Amirpours betörender Schwarz-Weißfilm „A Girl Walks Home Alone at Night“ ist ein Fest für Genre-Fans - und eine Metapher für die unterdrückte Stärke der iranischen Frauen.
öffnet in neuem Tab oder Fenster